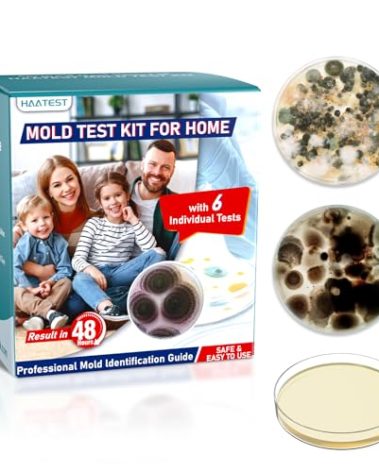
HAATEST Mold Test Kit for Home: 6 Simple Mold Detector with Detailed Identification Guide for Home Surfaces & Indoor Air Quality & HVAC Testing Results in 48 Hours - at Home Black Mold Detection Kit

Huma-i Smart (HI-300), Indoor Air Quality Monitor Which Measures CO2, VOC, Particle Matter (PM2.5 PM10 PM1.0), Temperature, Humidity with a Mobile app, Black
$179.00
- REAL-TIME AIR QUALITY MEASURE – air quality monitor with a mobile app measures levels of CO2, VOC (Volatile Organic Compounds) and Particle Matter (PM2.5/PM10/PM1.0). Also it measures temperature and Humidity. The measured air quality levels can be checked not only on the air quality monitor but also on the mobile app.
- CONNECTED WITH ALEXA AND IFTTT – It works with Alexa. In addition, you can monitor and manage your air quality monitor by interlocking with peripheral IoT devices via IFTTT.
- FREE MOBILE APP – App helps you track and manage your air quality anytime and anywhere. Change the pattern of your life that may be caused by air quality problems by tracking and managing the last 90 days of air quality data.
- PUSH MESSAGE AND ALARM – When the air quality changes from good to poor level, or from poor to good level, air quality is notified via push message. You can also monitor the air quality through the alarm function.
- SYSTEM REQUIREMENT – Android: Jelly Bean 4.1 or later, iOS: 9.0 or later, Wi-Fi: 2.4GHz only 802.11 b/g/n

There are no reviews yet.